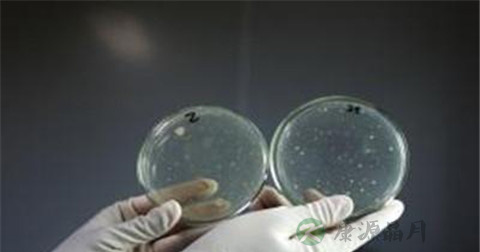

1、吲哚试验检查
以接种环接种待试细菌的新鲜斜面培养物于邓亨氏蛋白胨溶液中,37℃培养24~48小时后。于培养液中加入戊醇或二甲苯2~3ml,摇匀,静置片刻后,沿试管壁加入试剂2毫升。在戊醇或二甲苯下面的液体变红色者为阳性反应。也可将一指头大的脱脂棉,滴上两滴欧立希氏试剂,再在同处加滴两滴高硫酸钾饱和水溶液,置于含培养液的被检试管中,离液面约半寸,置烧杯内水浴煮沸为止,脱脂棉上出现红色为阳性。此法略繁,但省试剂且准确,因为将试剂加到液体中,吲哚和粪臭素均呈阳性,而用此法,只是吲哚(它能挥发)呈阳性反应。

2、特殊细菌涂片检查
在干净的载玻片上滴上一滴蒸馏水,用接种环进行无菌操作,挑取培养物少许,置载玻片的水滴中,与水混合做成悬液并涂成直径约1厘米的薄层,为避免因菌数过多聚成集团,不利观察个体形态,可在载玻片之一侧再加一滴水,从已涂布的菌液中再取一环于此水滴中进行稀释,涂布成薄层,若材料为液体培养物或固体培养物中洗下制备的菌液,则直接涂布于载玻片上即可。基本程序如下:制片→固定→媒染→染色→脱色→复染→水洗→干燥→镜检。根据各种细菌的形态特点,进行判断得出结论。
3、β-半乳糖苷酶试验检查
β-半乳糖苷酶试验是以有些细菌可产生β半乳糖苷酶,能分解邻硝基酚-β半乳糖苷(ONPG),生成黄色的邻硝基酚这样的原理进行的试验方法。
试剂采用0.75MONPG,溶液取80mg溶于15ml蒸馏水中,在加入缓冲液(6.9gNaH2P04溶于45ml蒸馏水中,用30%NaOH调整pH为7.0,再加水至50ml)5ml,置4℃冰箱中保存。取纯菌落用无菌生理盐水制成浓的菌悬液,加入0.25mlONPG液,置35℃水浴20min至3h,观察结果。结果判定:通常在20~30min内显色。出现黄色为阳性反应。
有些细菌可以分解色氨酸生成吲哚可以与二甲基氨基苯甲醛反应生成红色的玫瑰吲哚,因此可根据细菌能否分解色氨酸产生吲哚来鉴定菌种。异常结果:肠道的内环境不处于动态平衡,正常细菌的比例失调。痛、胃酸、胃胀、腹泻、腹痛、下坠、脓血便等症状,严重时还会引起消化道出血、穿孔、诱发癌变,如胃癌、结肠癌等。

埃希氏菌引起肠道外感染,特别是泌尿道感染。枸橼酸杆菌属引起原发性枸橼酸杆菌肺炎或继发性枸橼酸杆菌肺炎。病理改变主要表现为支气管肺炎,可有肺泡壁破坏形成小脓肿及局灶性出血。克雷伯菌属引起的呼吸道感染、败血症、化脓性脑膜炎、尿路感染等临床症状。还有沙门菌属、变形杆菌属等引起的各种异常症状;某些细菌水解淀粉并利用其水解产物,有产酸产气导致人体的不适。
需要检查的人群:有消化道出血、穿孔、诱发癌变等各种细菌感染症状者。
细菌的生理生化特征一直作为分类的主要依据。目前,以生理生化学作细菌分类的广泛采用方法有两种,即传统分类法和数值分类法。
1、传统分类法:传统分类的原则是将生物的基本性质分为主要的和次要的(主次原则),然后将主次顺序一级一级地往下分,直至最小区分。按细胞形态、革兰染色性、鞭毛及代谢特点作为较高一级分类依据。科、属、种水平的分类主要依靠生化特性和抗原结构。
2、数值分类法:数值分类法集数字、电子、信息及自动化分析技术于一体,将细菌的一些基本性质视为同等重要(等重要原则),采用标准化、成品化和配套生化反应试剂条,检测细菌的数十个生理生化特性。每个细菌都能产生一套阴阳性结果,然后转换成数字,通过电子计算机进行复杂计算,比较每一株与其他类同株,测定其相似度。根据相似度,区分细菌的种群,并确定各种细菌的亲缘关系。
豫公网安备 41110202000246号互联网药品信息服务资格证书:(豫)-经营性-2022-0039增值电信业务经营许可证:豫B2-20221313医疗器械经营备案编号:豫郑食药监械经营备20212188号



